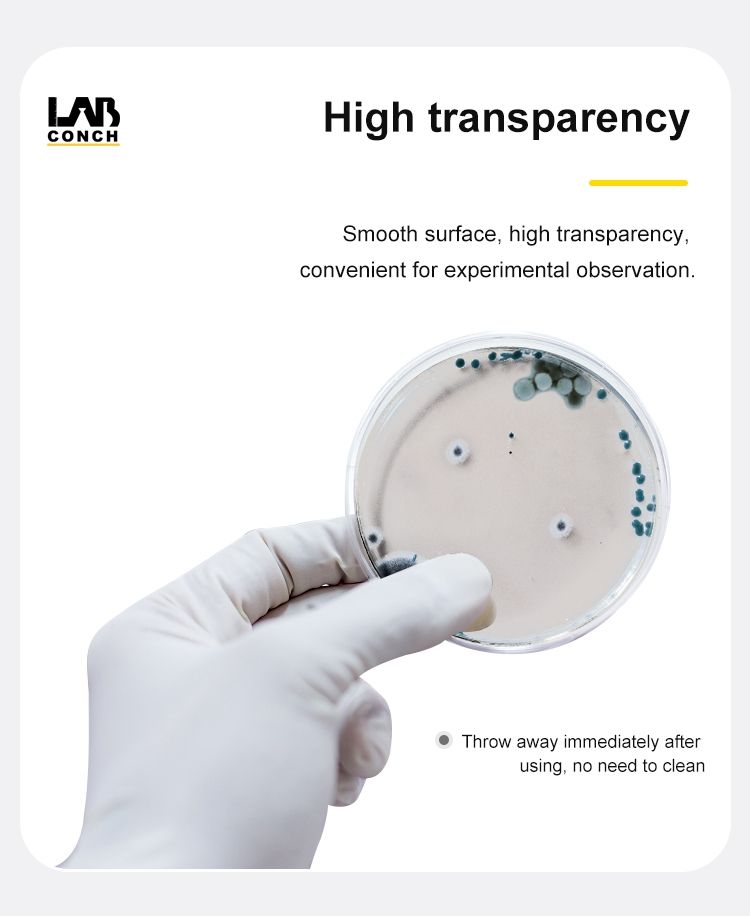

| model: | JBC049 | usage: | Medical Supplies |
| Certification: | International Organization for Standardization | Customization support: | OEM production |
| payment terms: | L/C, Western Union, T/T, Paypal | Package: | 10pcs/pack or single |
| Packaging Details: | AKM LAB High Transparent Polystyrene Petri Dish Standard Export Carton, Our packing is safe packing to prevent packing damage. | brand: | Experiment bench |
| Sterile: | EO sterile | application: | laboratory, chemistry, education, biology |
| Origin: | Zhejiang, China | type: | Four ventilation holes molded into the cover for gas exchange |
| Material: | High transparency polystyrene | product name: | petri dish plastic |
| feature: | smooth and free | Supply capacity: | 1,000,000 pieces of high transparent polystyrene Petri dishes per month |
| port: | Shanghai/Ningbo | Specification: | 35mm 60mm 100mm 150mm... |
| Classification: | petri dish | Advantage: | Digital code identifies where cells grow |

| PCR band | ||
![]() |
brand | Experiment bench |
| product name |
Disposable Plastic Petri Dish |
|
| 1. Smooth surface, best transparent body. | ||
| 2. EO sterilization is optional. | ||
| 3. Corrosion resistance, permeability, insulation. | ||
| 4. Packed in medical plastic bags, which can be individually packed. | ||
| 5. Uniform wall thickness ensures no deformation at the bottom, very stable. | ||
| 6. Cover ridge design for optimal gas exchange | ||
| 7. It is an ideal container for bacterial culture, and is also suitable for sample separation, pretreatment, storage... | ||
| No. | picture | Material | size | Packaging specifications. |
| JBC048 | ![]() |
polystyrene | φ35X15 | 2000pcs/box |
| JBC049 | ![]() |
φ60X15 | 1000pcs/box | |
| JBC050 | ![]() |
φ70X15 | 800pcs/box | |
| JBC051 | ![]() |
φ90X15 | 500pcs/box | |
| JBC052 | ![]() |
φ90X20 | 500pcs/box | |
| JBC053 | ![]() |
φ90X15 | 500pcs/box | |
| JBC054 | ![]() |
φ90X15 | 500pcs/box | |
| JBC055 | ![]() |
φ90X15 | 500pcs/box | |
| JBC056 | ![]() |
φ100X15 | 500pcs/box | |
| JBC057 | ![]() |
φ120X20 | 320pcs/box | |
| JBC058 | ![]() |
φ150X15 | 200pcs/box | |
| JBC059 | ![]() |
100x100x15mm, square, counting area |
500pcs/box | |
| JBC060 | ![]() |
130x130x15mm, square |
300pcs/box |

|
1. Can I get some samples? |
|
A: We are honored to send you samples for free according to our company regulations. Samples are free for your evaluation, but the courier fee needs to be paid by your company |
|
2. How about the delivery time? |
|
1) For sample order, it will be ready within 5 days. 2) For bulk order, it usually takes 20-30 days, depending on your quantity |
|
3. Can you do customization? |
|
OEM, ODM are all welcome. We can also help you design. 1). Silkscreen your logo on the product; |
|
4. How about payment? |
|
1). The amount is less than USD 1000, you can pay for the order by Paypal, Western Union 3).Alibaba trade assurance payment |
|
5. How about the shipping cost? |
|
1) For sample order, it will be sent by express company such as UPS, Fedex, TNT, etc. We have a strong relationship with them, if you have a courier account, you don't need to pay us. 2) For bulk order, it will be sent by sea. We have our cooperative forwarder, you can also use your forwarder. |
|
6. How about your after-sales service? |
|
1) Any inquiry will be replied within 24 hours 2) Professional manufacturer, quality matter, competitive price 3) All products will be strictly quality checked and properly packed before shipment 4) If you order a full box and it is damaged more than 2%, we will replace it for you next time. |
|
7. Can you tell me your main customers? |
|
Sorry, we can't tell you unless the client allows us to. At the same time, your information will also be protected. |
|
If you have any confusion and questions, please feel free to contact us. |